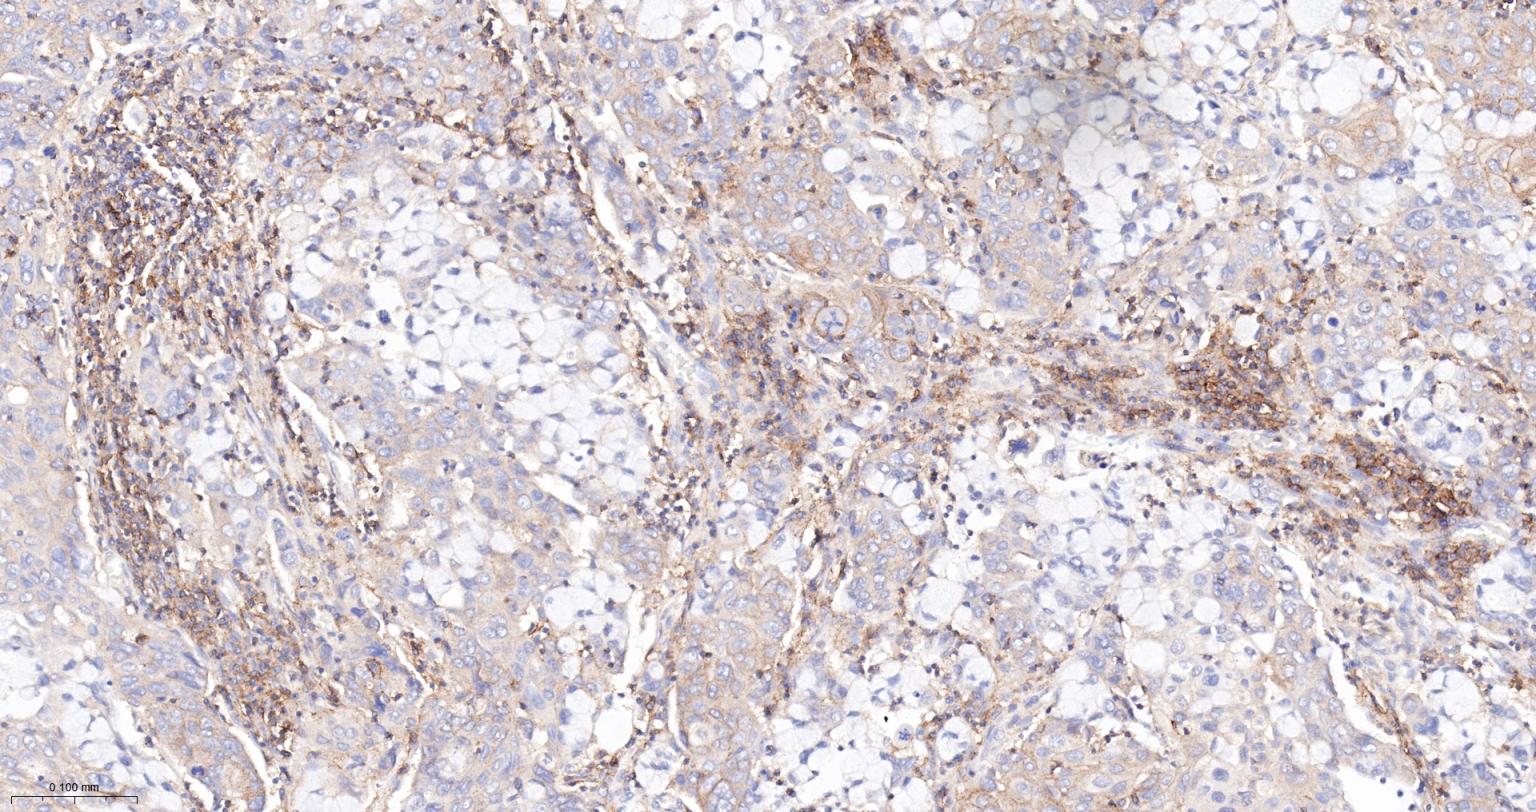
一种肿瘤抑制基因抗体
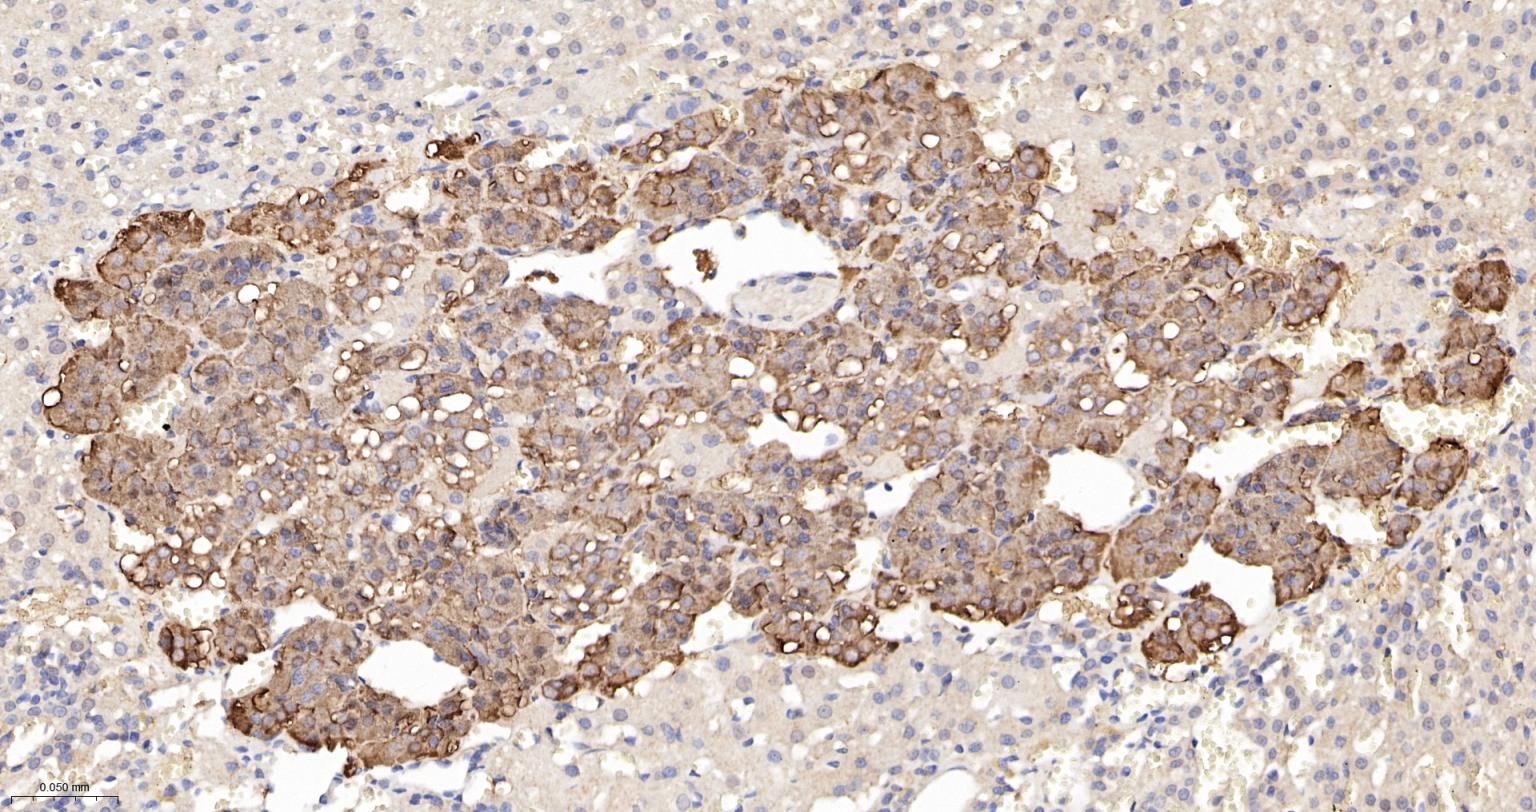
一种肿瘤抑制基因抗体
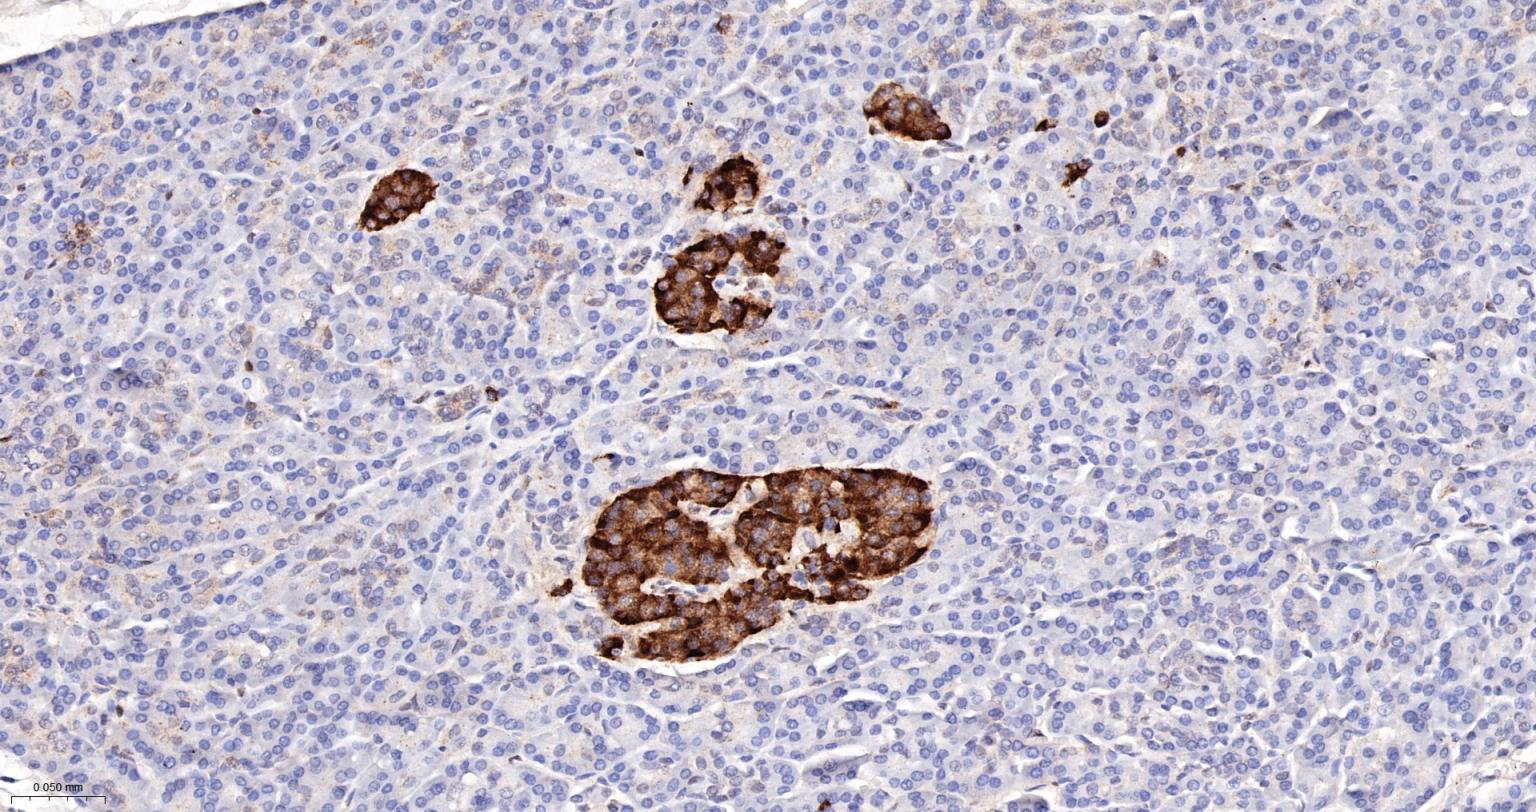
一种肿瘤抑制基因抗体

PTEN Recombinant Rabbit mAb (一抗) - WB,IHC-P,IHC-F,IF,ELISA | Bioss
Rrmab?兔单抗

货号:bsm-52369R
产品详情
相关标记
相关产品
相关文献
常见问题
概述
产品编号
bsm-52369R
产品类型
重组兔单抗
英文名称
PTEN Recombinant Rabbit mAb
中文名称
一种肿瘤抑制基因抗体
英文别名
10q23del; BZS; CWS1; DEC; GLM2; MHAM; MMAC1; PTEN1; PTENbeta; PTENgama; TEP1; 2310035O07Rik; A130070J02Rik; B430203M17Rik; Mmac; PTEN_HUMAN; PTEN; Inositol polyphosphate 3-phosphatase; Mutated in multiple advanced cancers 1; Phosphatase and tensin homolog; 3.1.3.16; 3.1.3.48; 3.1.3.67; PTEN_MOUSE;
抗体来源
Rabbit
免疫原
A synthesized peptide derived from human PTEN: 350-403
亚型
IgG
性状
Liquid
纯化方法
affinity purified by Protein A
克隆类型
Recombinant
克隆号
9D2
理论分子量
44 kDa
检测分子量
53 kDa
浓度
1mg/ml
储存液
0.01M TBS (pH7.4) with 1% BSA, 0.02% Proclin300 and 50% Glycerol.
研究领域
Cancer > Cell cycle > Kinases/phosphatases > Phosphatases
Cancer > Oncoproteins/suppressors > Tumor suppressors > PTEN pathway
Cell Biology > Cell Cycle > Kinases/Phosphatases > Phosphatases
Epigenetics and Nuclear Signaling > Transcription > Cancer susceptibility > Tumor Suppressors
Metabolism > Types of disease > Diabetes
Metabolism > Types of disease > Metabolic disorders
Metabolism > Types of disease > Obesity
Signal Transduction > Signaling Pathway > Lipid Signaling > Lipid Phosphatases
SWISS
Gene ID
保存条件
Shipped at 4℃. Store at -20℃ for one year. Avoid repeated freeze/thaw cycles.
注意事项
This product as supplied is intended for research use only, not for use in human, therapeutic or diagnostic applications.
数据库链接
产品介绍
PTEN是一种肿瘤抑制基因(C端抗体),在维持细胞的增殖、分化和凋亡平衡起重要作用,该基因在许多肿瘤常表现为突变或杂合性丢失,NMAC1主要用于胶质瘤、乳腺、前列腺癌、非何杰金氏淋巴瘤各种恶性肿瘤的研究.
背景资料
Potential tumor suppressor. Acts as a phosphoinositide3-phosphatase by regulating PtdIns (3,4,5)P3 levels. Involved in regulation of the AKT1 signaling pathway. The unphosphorylated form cooperates with AIP1 to suppress AKT1 activation.The PTEN/MMAC1 discovers the first to have the suppress of the phosphoric acid enzyme activity cancer gene currently.The gene of PTEN locates the chromosome10q23 area, sending forth sex tumor and a few households cancers with the variety to suffer from the comprehensive disease easilyrelevant.The activity that passes to repress the Akt regulates the cell period, the cell ground rule decease and glues to connect.This text discussed PTEN structure, function and its correlationses, the PTEN is in tumor repress function mechanism.

产品应用
| 应用 | 已检合格种属 | 预测种属 | 推荐稀释比例 |
|---|---|---|---|
| WB | Human, Mouse, Rat | 1:1000-2000 | |
| IHC-P | Human, Mouse, Rat | 1:200-500 | |
| IHC-F | Human, Mouse, Rat | 1:200-500 | |
| IF | Human, Mouse, Rat | 1:200-500 | |
| ELISA | Human, Mouse, Rat | 1:5000-10000 |
交叉反应
交叉反应: Human, Mouse, Rat
相关产品
暂无相关产品
靶标
基因名
PTEN
蛋白名
Phosphatidylinositol 3, 4, 5-trisphosphate 3-phosphatase and dual-specificity protein phosphatase PTEN
亚基
Monomer. The unphosphorylated form interacts with the second PDZ domain of AIP1 and with DLG1 and MAST2 in vitro. Interacts with MAGI2, MAGI3, MAST1 and MAST3, but neither with MAST4 nor with DLG5. Interaction with MAGI2 increases protein stability. Interacts with NEDD4. Interacts with NDFIP1 and NDFIP2; in the presence of NEDD4 or ITCH, this interaction promotes PTEN ubiquitination. Interacts (via C2 domain) with FRK. Interacts with USP7; the interaction is direct. Interacts with ROCK1. Interacts with XIAP/BIRC4.
亚细胞定位
Cytoplasm. Nucleus. Nucleus, PML body. Note=Monoubiquitinated form is nuclear. Nonubiquitinated form is cytoplasmic. Colocalized with PML and USP7 in PML nuclear bodies. XIAP/BIRC4 promotes its nuclear localization.
组织特异性
Expressed at a relatively high level in all adult tissues, including heart, brain, placenta, lung, liver, muscle, kidney and pancreas.
翻译后修饰
Constitutively phosphorylated by CK2 under normal conditions. Phosphorylated in vitro by MAST1, MAST2 and MAST3. Phosphorylation results in an inhibited activity towards PIP3. Phosphorylation can both inhibit or promote PDZ-binding. Phosphorylation at Tyr-336 by FRK/PTK5 protects this protein from ubiquitin-mediated degradation probably by inhibiting its binding to NEDD4. Phosphorylation by ROCK1 is essential for its stability and activity. Phosphorylation by PLK3 promotes its stability and prevents its degradation by the proteasome.
Monoubiquitinated; monoubiquitination is increased in presence of retinoic acid. Deubiquitinated by USP7; leading to its nuclear exclusion. Monoubiquitination of one of either Lys-13 and Lys-289 amino acid is sufficient to modulate PTEN compartmentalization. Ubiquitinated by XIAP/BIRC4.
Monoubiquitinated; monoubiquitination is increased in presence of retinoic acid. Deubiquitinated by USP7; leading to its nuclear exclusion. Monoubiquitination of one of either Lys-13 and Lys-289 amino acid is sufficient to modulate PTEN compartmentalization. Ubiquitinated by XIAP/BIRC4.
疾病
Defects in PTEN are a cause of Cowden disease (CD) [MIM:158350]; also known as Cowden syndrome (CS). CD is an autosomal dominant cancer predisposition syndrome associated with elevated risk for tumors of the breast, thyroid and skin. The predominant phenotype for CD is multiple hamartoma syndrome, in many organ systems including the breast (70% of CD patients), thyroid (40-60%), skin, CNS (40%), gastrointestinal tract. Affected individuals are at an increased risk of both breast and thyroid cancers. Trichilemmomas (benign tumors of the hair follicle infundibulum), and mucocutaneous papillomatosis (99%) are hallmarks of CD.
Defects in PTEN are the cause of Lhermitte-Duclos disease (LDD) [MIM:158350]; also known as cerebelloparenchymal disorder VI. LDD is characterized by dysplastic gangliocytoma of the cerebellum which often results in cerebellar signs and seizures. LDD and CD seem to be the same entity, and are considered as hamartoma-neoplasia syndromes.
Defects in PTEN are a cause of Bannayan-Zonana syndrome (BZS) [MIM:153480]; also known as Ruvalcaba-Myhre-Smith syndrome (RMSS) or Bannayan-Riley-Ruvalcaba syndrome (BRRS). In BZS there seems not to be an increased risk of malignancy. It has a partial clinical overlap with CD. BZS is characterized by the classic triad of macrocephaly, lipomatosis and pigmented macules of the gland penis.
Defects in PTEN are a cause of head and neck squamous cell carcinomas (HNSCC) [MIM:275355]; also known as squamous cell carcinoma of the head and neck.
Defects in PTEN are a cause of susceptibility to endometrial cancer (ENDMC) [MIM:608089].
Note=PTEN mutations are found in a subset of patients with Proteus syndrome, a genetically heterogeneous condition. The molecular diagnosis of PTEN mutation positive cases classifies Proteus syndrome patients as part of the PTEN hamartoma syndrome spectrum. As such, patients surviving the early years of Proteus syndrome are likely at a greater risk of developing malignancies.
Defects in PTEN are a cause of susceptibility to glioma type 2 (GLM2) [MIM:613028]. Gliomas are central nervous system neoplasms derived from glial cells and comprise astrocytomas, glioblastoma multiforme, oligodendrogliomas, and ependymomas.
[DISEASE] Defects in PTEN are a cause of VACTERL association with hydrocephalus (VACTERL-H) [MIM:276950]. VACTERL is an acronym for vertebral anomalies, anal atresia, congenital cardiac disease, tracheoesophageal fistula, renal anomalies, radial dysplasia, and other limb defects.
Defects in PTEN may be a cause of susceptibility to prostate cancer (PC) [MIM:176807]. It is a malignancy originating in tissues of the prostate. Most prostate cancers are adenocarcinomas that develop in the acini of the prostatic ducts. Other rare histopathologic types of prostate cancer that occur in approximately 5% of patients include small cell carcinoma, mucinous carcinoma, prostatic ductal carcinoma, transitional cell carcinoma, squamous cell carcinoma, basal cell carcinoma, adenoid cystic carcinoma (basaloid), signet-ring cell carcinoma and neuroendocrine carcinoma.
Defects in PTEN are a cause of macrocephaly/autism syndrome (MCEPHAS) [MIM:605309]. Patients have autism spectrum disorders and macrocephaly, with head circumferences ranging from +2.5 to +8 SD for age and sex (average head circumference +4.0 SD).
Note=A microdeletion of chromosome 10q23 involving BMPR1A and PTEN is a cause of chromosome 10q23 deletion syndrome, which shows overlapping features of the following three disorders: Bannayan-Zonana syndrome, Cowden disease and juvenile polyposis syndrome.
Defects in PTEN are the cause of Lhermitte-Duclos disease (LDD) [MIM:158350]; also known as cerebelloparenchymal disorder VI. LDD is characterized by dysplastic gangliocytoma of the cerebellum which often results in cerebellar signs and seizures. LDD and CD seem to be the same entity, and are considered as hamartoma-neoplasia syndromes.
Defects in PTEN are a cause of Bannayan-Zonana syndrome (BZS) [MIM:153480]; also known as Ruvalcaba-Myhre-Smith syndrome (RMSS) or Bannayan-Riley-Ruvalcaba syndrome (BRRS). In BZS there seems not to be an increased risk of malignancy. It has a partial clinical overlap with CD. BZS is characterized by the classic triad of macrocephaly, lipomatosis and pigmented macules of the gland penis.
Defects in PTEN are a cause of head and neck squamous cell carcinomas (HNSCC) [MIM:275355]; also known as squamous cell carcinoma of the head and neck.
Defects in PTEN are a cause of susceptibility to endometrial cancer (ENDMC) [MIM:608089].
Note=PTEN mutations are found in a subset of patients with Proteus syndrome, a genetically heterogeneous condition. The molecular diagnosis of PTEN mutation positive cases classifies Proteus syndrome patients as part of the PTEN hamartoma syndrome spectrum. As such, patients surviving the early years of Proteus syndrome are likely at a greater risk of developing malignancies.
Defects in PTEN are a cause of susceptibility to glioma type 2 (GLM2) [MIM:613028]. Gliomas are central nervous system neoplasms derived from glial cells and comprise astrocytomas, glioblastoma multiforme, oligodendrogliomas, and ependymomas.
[DISEASE] Defects in PTEN are a cause of VACTERL association with hydrocephalus (VACTERL-H) [MIM:276950]. VACTERL is an acronym for vertebral anomalies, anal atresia, congenital cardiac disease, tracheoesophageal fistula, renal anomalies, radial dysplasia, and other limb defects.
Defects in PTEN may be a cause of susceptibility to prostate cancer (PC) [MIM:176807]. It is a malignancy originating in tissues of the prostate. Most prostate cancers are adenocarcinomas that develop in the acini of the prostatic ducts. Other rare histopathologic types of prostate cancer that occur in approximately 5% of patients include small cell carcinoma, mucinous carcinoma, prostatic ductal carcinoma, transitional cell carcinoma, squamous cell carcinoma, basal cell carcinoma, adenoid cystic carcinoma (basaloid), signet-ring cell carcinoma and neuroendocrine carcinoma.
Defects in PTEN are a cause of macrocephaly/autism syndrome (MCEPHAS) [MIM:605309]. Patients have autism spectrum disorders and macrocephaly, with head circumferences ranging from +2.5 to +8 SD for age and sex (average head circumference +4.0 SD).
Note=A microdeletion of chromosome 10q23 involving BMPR1A and PTEN is a cause of chromosome 10q23 deletion syndrome, which shows overlapping features of the following three disorders: Bannayan-Zonana syndrome, Cowden disease and juvenile polyposis syndrome.
相似性
Contains 1 C2 tensin-type domain.
Contains 1 phosphatase tensin-type domain.
Contains 1 phosphatase tensin-type domain.
功能
Tumor suppressor. Acts as a dual-specificity protein phosphatase, dephosphorylating tyrosine-, serine- and threonine-phosphorylated proteins. Also acts as a lipid phosphatase, removing the phosphate in the D3 position of the inositol ring from phosphatidylinositol 3,4,5-trisphosphate, phosphatidylinositol 3,4-diphosphate, phosphatidylinositol 3-phosphate and inositol 1,3,4,5-tetrakisphosphate with order of substrate preference in vitro PtdIns(3,4,5)P3 > PtdIns(3,4)P2 > PtdIns3P > Ins(1,3,4,5)P4. The lipid phosphatase activity is critical for its tumor suppressor function. Antagonizes the PI3K-AKT/PKB signaling pathway by dephosphorylating phosphoinositides and thereby modulating cell cycle progression and cell survival. The unphosphorylated form cooperates with AIP1 to suppress AKT1 activation. Dephosphorylates tyrosine-phosphorylated focal adhesion kinase and inhibits cell migration and integrin-mediated cell spreading and focal adhesion formation. Plays a role as a key modulator of the AKT-mTOR signaling pathway controlling the tempo of the process of newborn neurons integration during adult neurogenesis, including correct neuron positioning, dendritic development and synapse formation. May be a negative regulator of insulin signaling and glucose metabolism in adipose tissue. The nuclear monoubiquitinated form possesses greater apoptotic potential, whereas the cytoplasmic nonubiquitinated form induces less tumor suppressive ability.
同靶标产品
相关文献
提示: 发表研究结果有使用 bsm-52369R 时请让我们知道,以便我们可以引用参考文章。作为回馈,资料提供者将获得我们送上的小礼品。
具体参考文献:bsm-52369R 被引用于1文献中